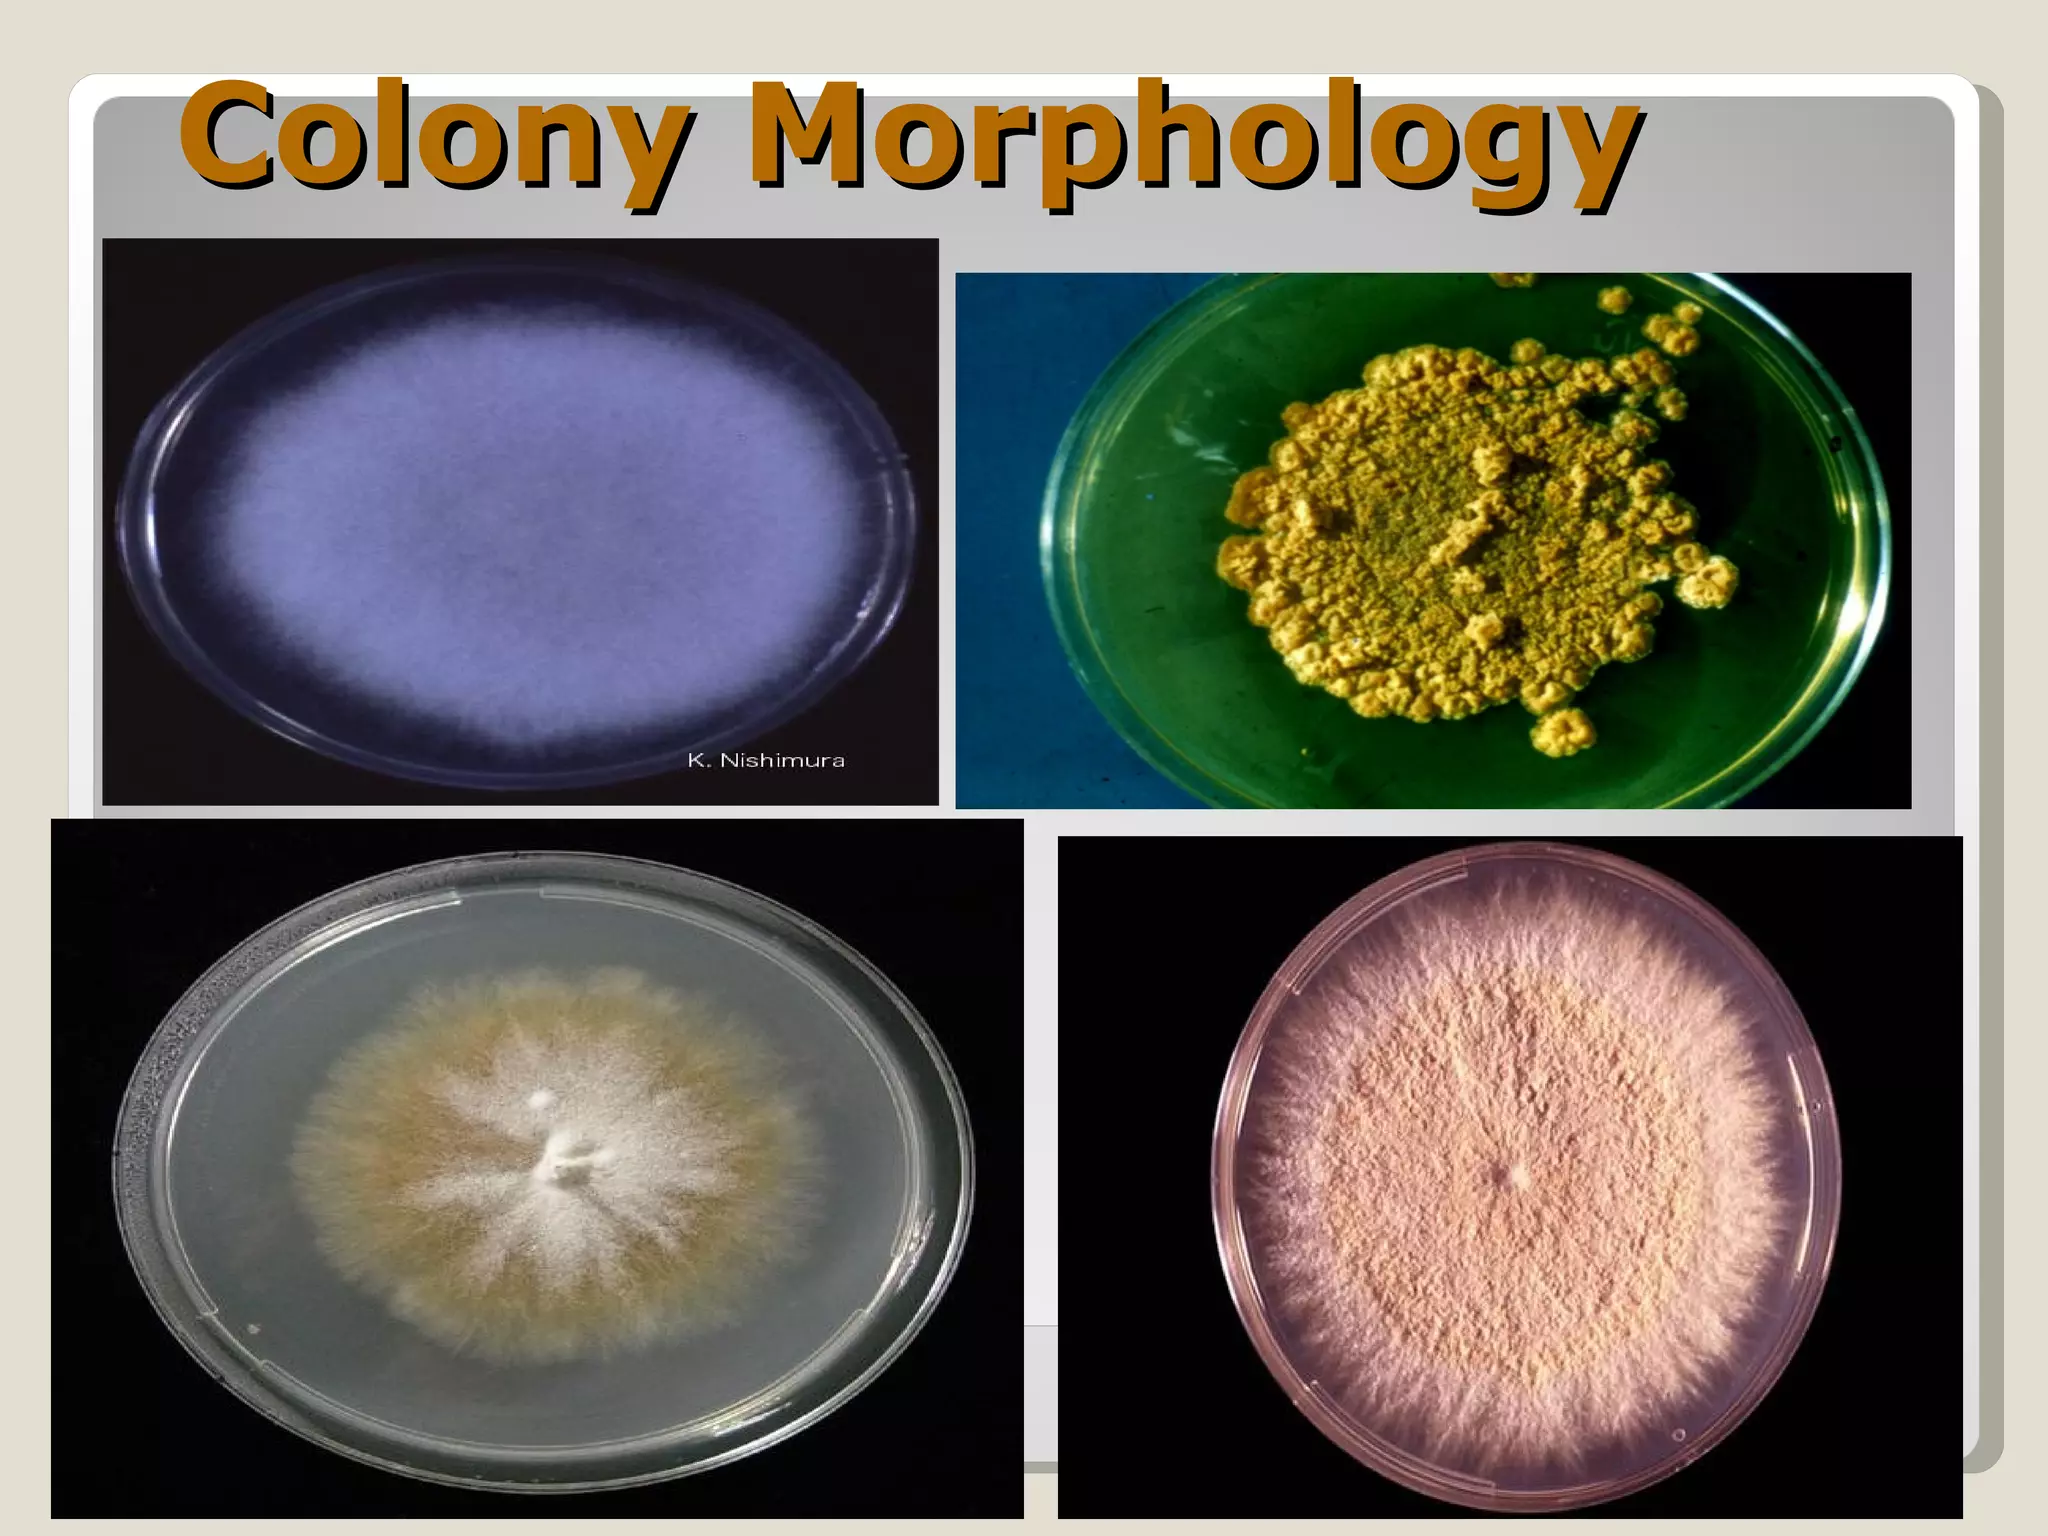
Colony Morphology
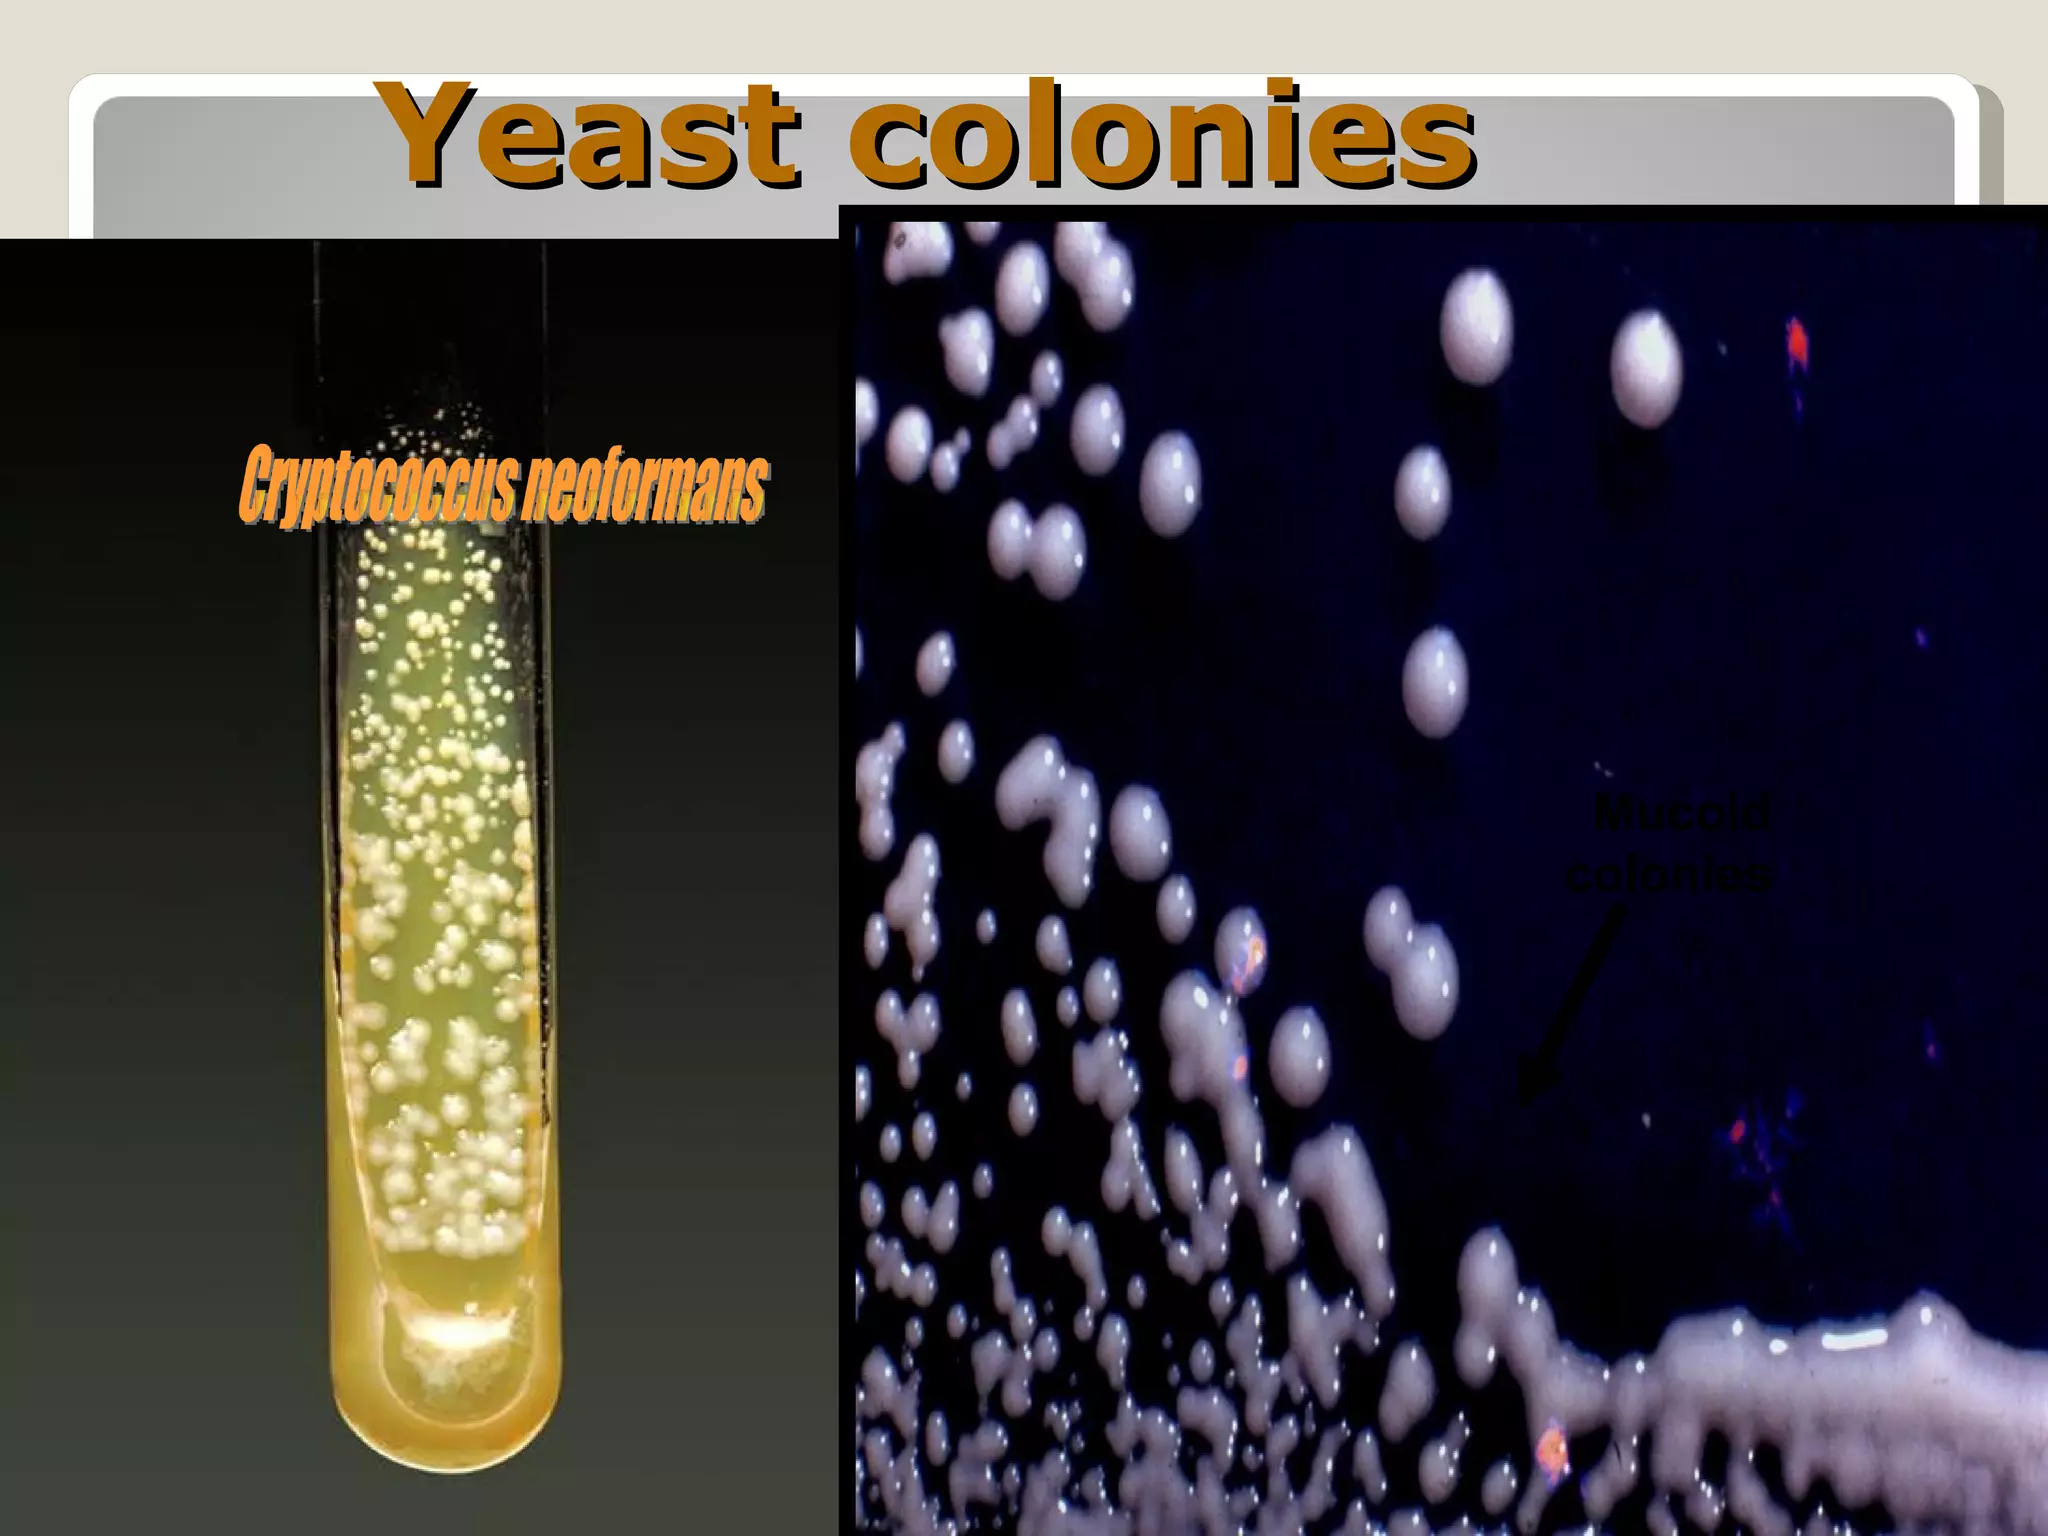
Yeast colonies



                  Mucoid
                 colonies
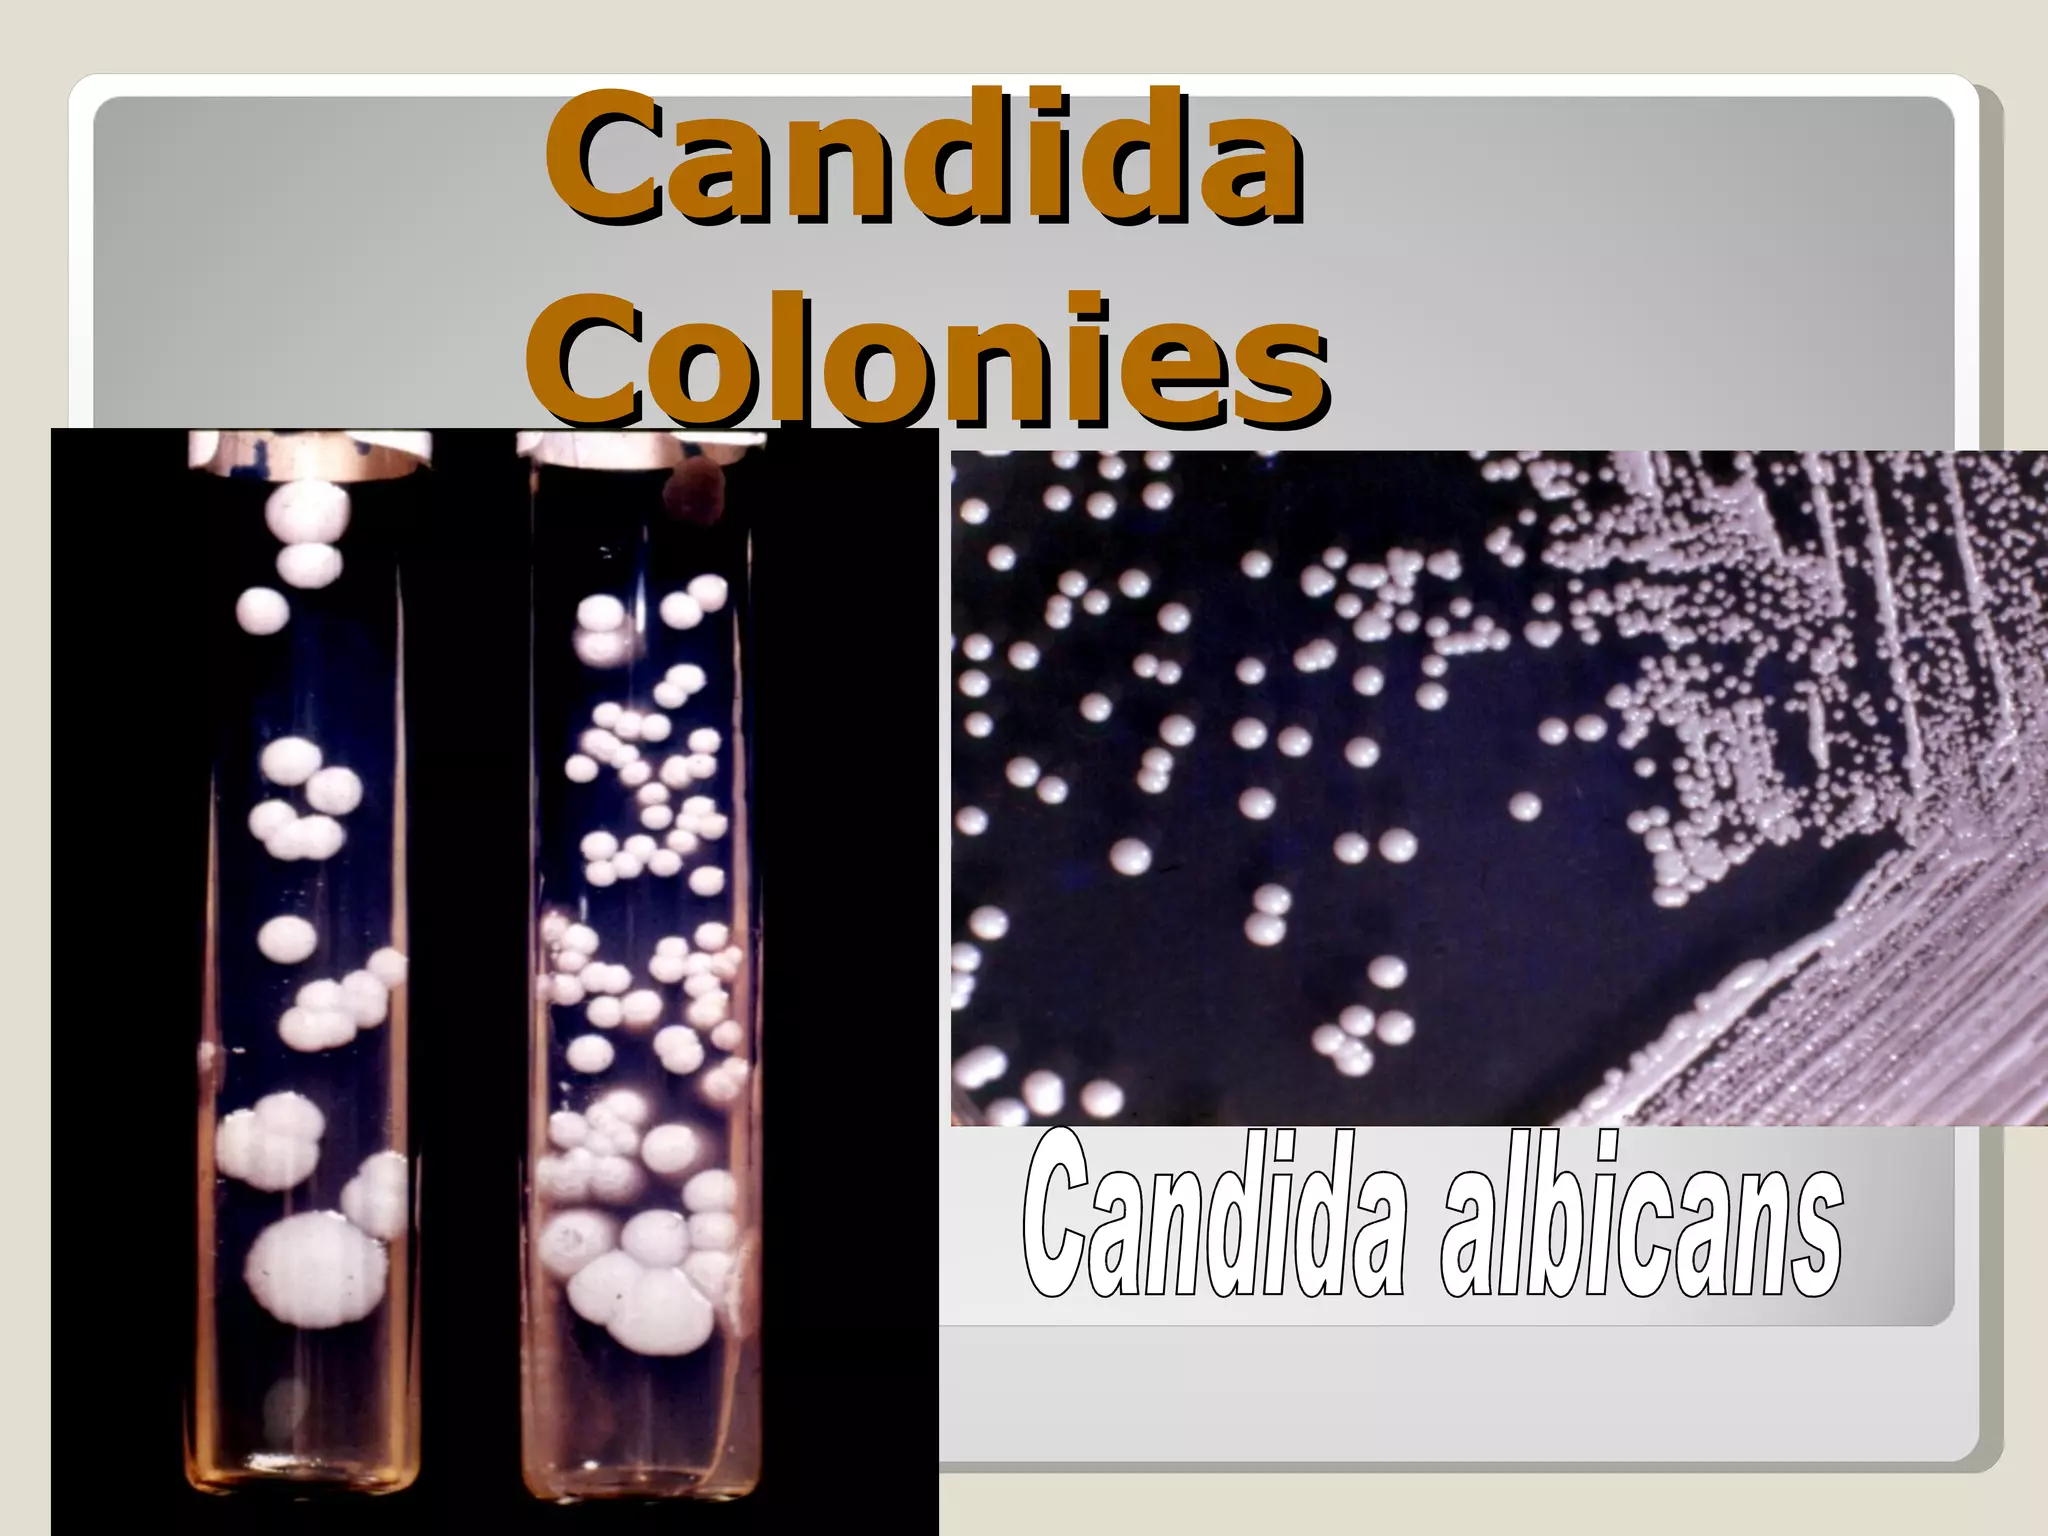
Candida
Colonies
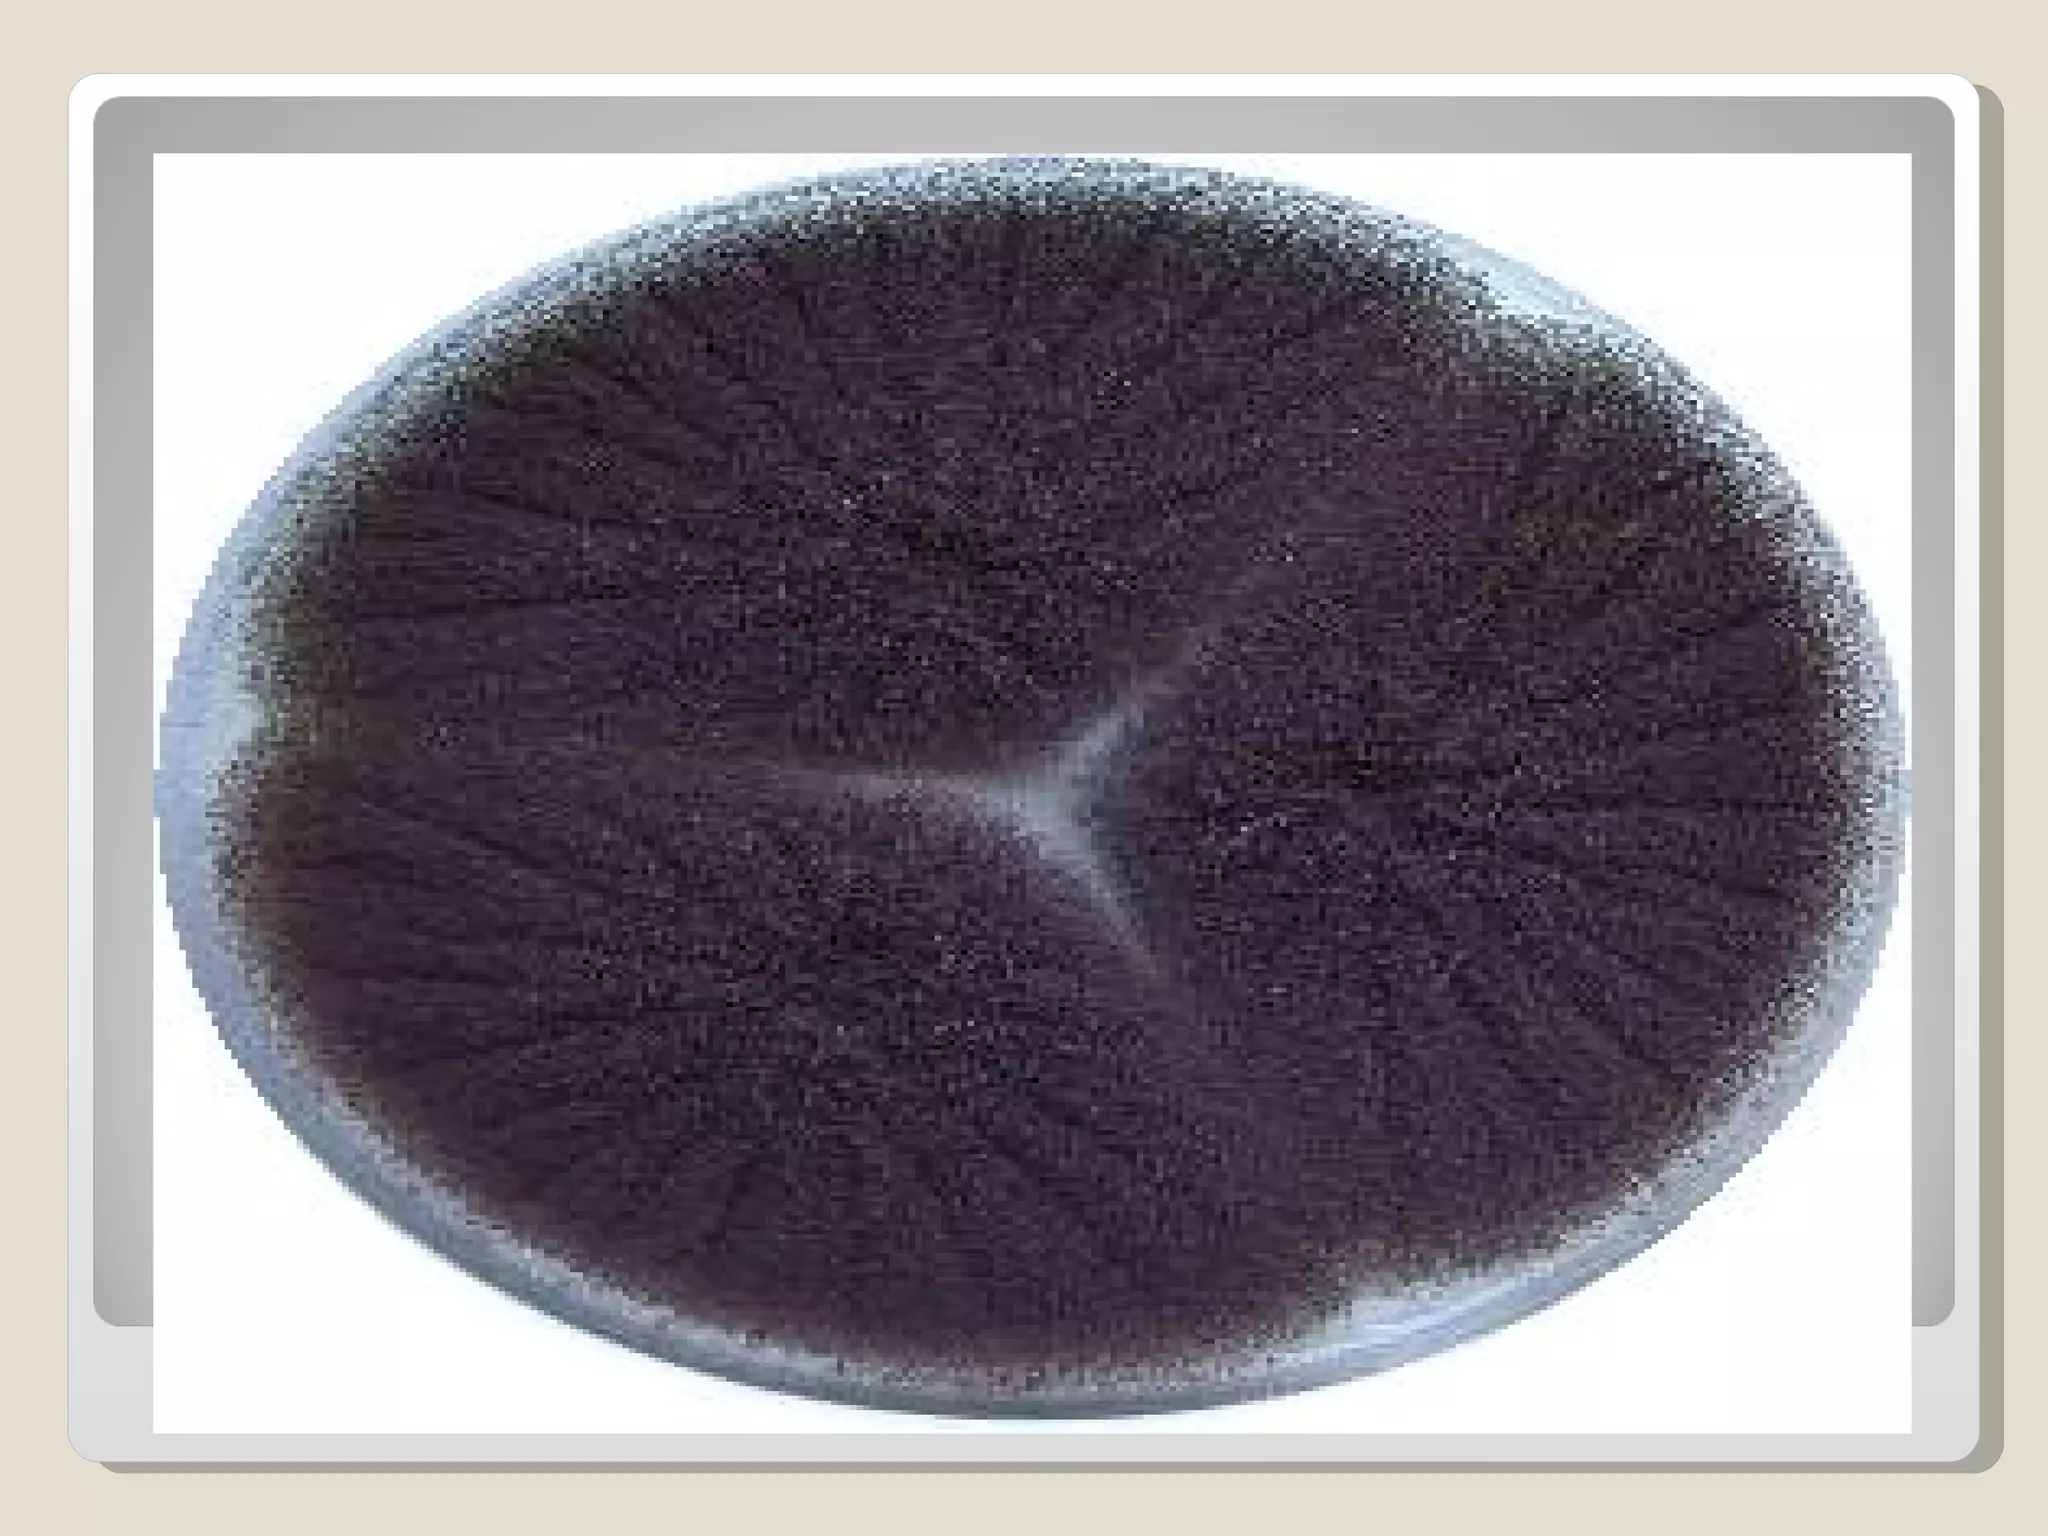

The document discusses medical mycology, which is the study of pathogenic fungi that cause disease. It covers topics such as the classification of fungi, their modes of reproduction, pathogenesis of fungal infections, diagnosis of fungal diseases, and antifungal therapies. The major classes of antifungal drugs are discussed including polyenes, azoles, and echinocandins which act on the fungal cell membrane or cell wall.